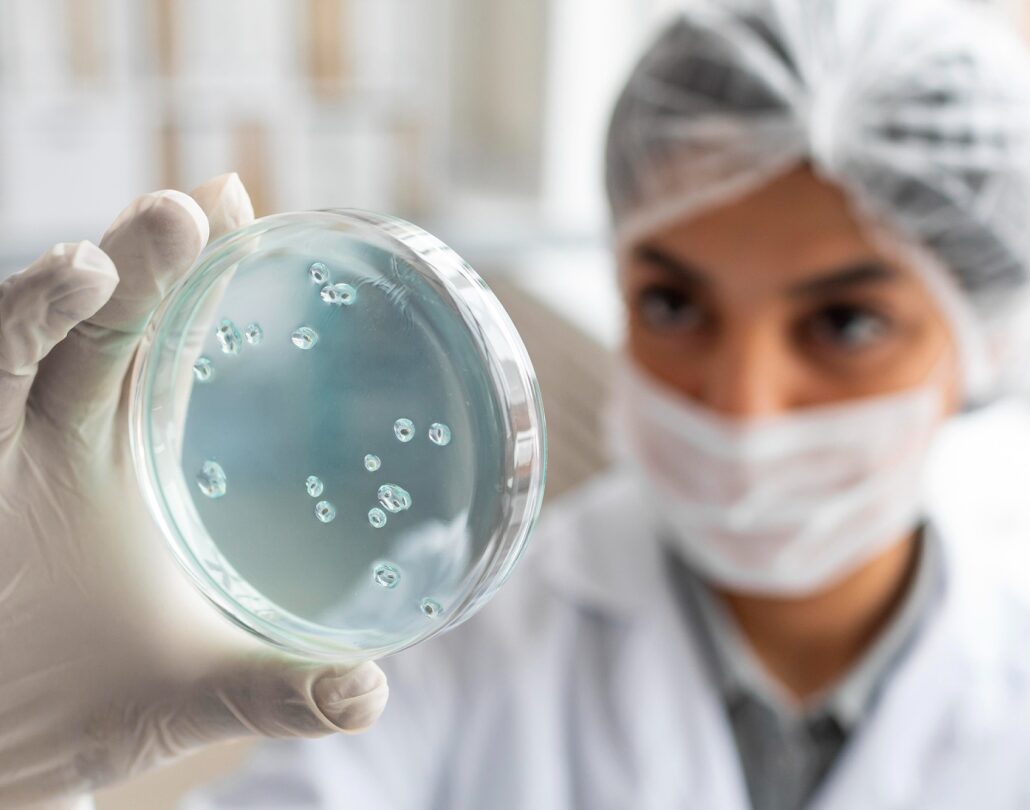

Seis (6) bioreactores Marca Applikon de (500 mL). completamente equipados y con un software que permite un monitoreo y control automático en línea

Transformamos la ciencia en experiencia y aprendizaje.
El laboratorio de Biocatálisis y Fermentación de la Icesi, es el lugar donde integramos conocimientos y tecnologías para implementar y evaluar diversas estrategias de fermentación y transformación biocatalítica.

Seis (6) bioreactores Marca Applikon de (500 mL). completamente equipados y con un software que permite un monitoreo y control automático en línea

Centrifugas de mesa para operaciones de separación.

Incubadoras estáticas y con agitación orbital

Cabina de bioseguridad.